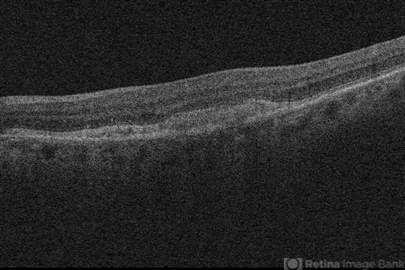

File number: 18548
Comments
-
John S. King, MD (June 29 2014)
Fairly homogenous material between the RPE and PR. No srf, cme, or leakage on FA
Sign in to comment.
-
By John S. King, MD
Retina Associates, PA - Uploaded on Jun 29, 2014.
- Last modified by Caroline Bozell on Jun 30, 2014.
- Rating
- Appears in
- Miscellaneous
- Condition/keywords
- aquired vitelliform maculopathy
- Photographer
- Wayne A Ladlee Jr
- Imaging device
-
Optical coherence tomography system
Cirrus - Description
- Initial presentation.